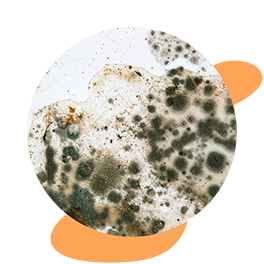

Weatherbond AquaGuard
Exterior Paints

Weatherbond AquaGuard

Benefits
![]()
Enhanced protection against water ingress

Good efflorescence & alkaline resistance
![]()
Excellent fungal and algal resistance
Features
![]()
Does not contain lead and mercury
![]()
Does not contain heavy metals
![]()
Free from Alkylphenol Ethoxylate (APEO) & formaldehyde
Finish
![]()
Matt
Use This Paint If...

You want excellent flexibility with good crack bridging property for exterior surfaces

You want an exterior paint with effective protection against water ingress and environmental exposure
You do not want to worry about the growth of fungus or algae on your walls
Where Can You Use It?
Perfect to use as a positive-side waterproofing coating for the protection of vertical concrete and other masonry surfaces.

METHOD:
Roller or brush
THEORETICAL COVERAGE:
DRYING TIME:
Touch Dry – 10 minutes at 30°C
Hard Dry – 30 minutes at 30°C
OVERCOATING TIME:
2 hours minimum based on normal conditions
Ensure surface is clean, dry and stable using the following suggested surface treatments:
- Moisture: The surface must be completely dry and free of any water residue. Moisture must be <4% (Sovereign moisture master / Tramex moisture meter) before application
- Unstable matter: Remove any loose or unstable material such as peeling paint, rust, mill scale, and dirt by high-pressure water jet wash or mechanical means such as power brush or scraper, whichever is appropriate
- Contaminants: Clean the surface of any dust, dirt, oil, or grease using a damp cloth and, if necessary, a mild detergent or solvent. Allow the surface to dry completely
- Fungus and Algae: Wash the affected area to remove unstable materials and microorganisms, and then apply an anti- fungus solution and leave it on for at least 2 hours
- Hairline cracks: Fill any hairline cracks with a suitable exterior- grade, water-resistant putty or filler
You might also be interested in
Also bought with
Why Nippon Paint?

Nippon Paint is Singapore's No.1 Paint Brand.

Nippon Paint is one of the most established pioneers in the paint industry with more than 120 years of experience in paint technology.

Nippon Paint strictly complies with local quality, environmental, occupational health and safety, legal and other requirements to ensure highest quality is met.






